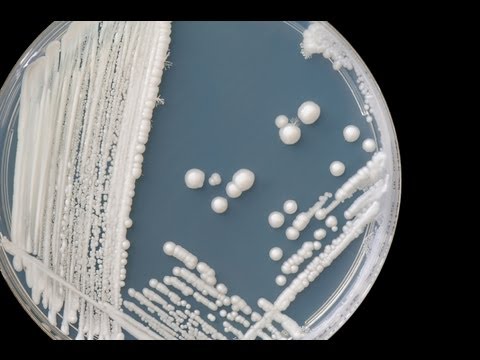

Vaginal yeast infections are common in women. The symptoms amd causes are easily recognizable. Frequent yeast infections may indicate an underlying condition.
- Category
- Health & Beauty
Be the first to comment
Up Next
Autoplay
-
The Surprising Thing That Could Be Causing Your Yeast Infection
by ava 172 Views -
Spring Break Partiers Pack Florida Hotspots As U.S. Infections Rise
by lily 122 Views -
Dealing with Infections
by Danielle 219 Views -
Global measles infections on the rise | DW News
by lily 158 Views -
How to Treat Urinary Tract Infections Naturally
by Danielle 791 Views -
Garlic Green Onion Naan - Fast No-Yeast No-Rise Method - Food Wishes
by AVA 126 Views -
How to Spot and Treat Fungal Nail Infections
by Danielle 138 Views -
Recurring Strep Throat Infections Explained!
by Danielle 156 Views -
Hospital Infections in US Continue to Rise
by star 623 Views -
TASTY NO YEAST PIZZA - Easy food recipes for dinner to make at home
by AVA 232 Views -
Infections - WW1 Uncut - BBC
by Danielle 232 Views -
Yeast Infection Prevention Tips
by ava 177 Views -
How I Treating Respiratory Infections
by admin 143 Views -
Austrian Germknödel - Yeast Dumpling
by ava 177 Views -
Yeast in Mashed Potatoes
by AVA 135 Views -
How To Prevent Yeast Infections
by AVA 230 Views -
Sharp increase in coronavirus infections explained | DW News
by lily 116 Views -
Homemade Yeast Dinner Rolls Recipe - How to Bake Homemade Rolls
by AVA 196 Views -
How To Know If You Have Yeast Infection
by AVA 218 Views -
Why?! Causes: Advanced English Vocabulary to Talk about Causes. Collocations and Idioms for IELTS!
by lily 139 Views -
Coronavirus infections skyrocket on cruise ship in Japan | DW News
by lily 163 Views -
Finally, a Drug That Helps With the Worst COVID-19 Infections
by AVA 213 Views -
This Fruit Could Treat Parkinson's... Even Though It Causes Parkinson's Symptoms
by AVA 124 Views -
Flowers, Bees, and... Yeast? It's a Pollination Love Triangle!
by AVA 146 Views
Add to playlist
Sorry, only registred users can create playlists.